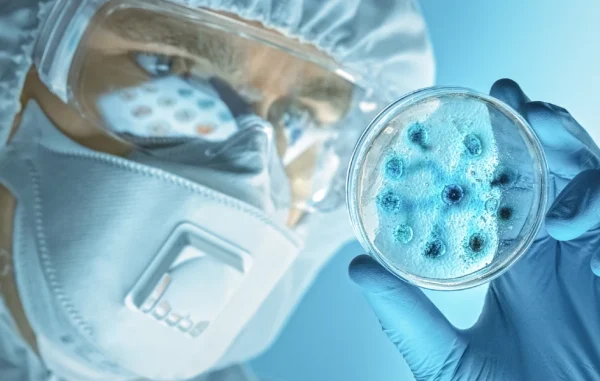

Ο Ελληνικός Ερυθρός Σταυρός ενώνει τις δυνάμεις του με τον αθλητή μεγάλων αποστάσεων Σωτήρη Μπαρμπαρόσο με αφορμή την Παγκόσμια Ημέρα Κατά του Καρκίνου του Μαστού.
Καρκίνος του μαστού
Φωταγώγηση Δημοτικού Θεάτρου Λαμίας στο πλαίσιο της Παγκόσμιας Ημέρας Καρκίνου του Μαστού
Η πρωτοβουλία εντάσσεται σε σειρά δράσεων που στοχεύουν στην ευαισθητοποίηση του κοινού σχετικά με την σημασία της πρόληψης και της έγκαιρης διάγνωσης.
«Με το "ΠΡΟΛΑΜΒΑΝΩ" η χώρα μας διαθέτει ένα οργανωμένο πρόγραμμα πρόληψης της ασθένειας» τονίζει η αναπληρώτρια υπουργός Υγείας Ειρήνη Αγαπηδάκη.